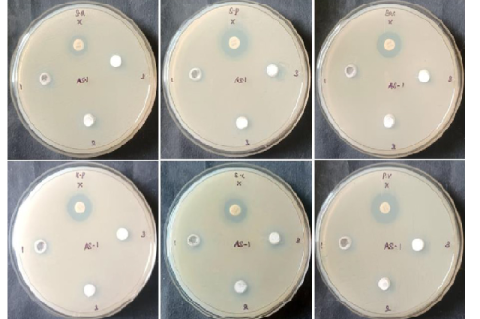
Antibacterial activity of GABT NPs treated with S. aureus, S. pneumoniae, B. subtilis, K. pneumoniae, E. coli, and P. vulgaris bacterial strain.

Asian Journal of Biological and Life sciences, Vol 12, Issue 2, May-Aug, 2023
Recent Articles
Review Article
HLA Allele Type Prediction: A Review on Concepts, Methods and Algorithms
Balamurugan Sivaprakasam,Prasanna Sadagopan
Asian J. Biol. Life Sci.,12(2):206-215 DOI: 10.5530/ajbls.2023.12.29 Published: Fri, 22-Sep-2023 Read More
Review Article
The Prevalence of Soil-Transmitted Helminths (STH) and Entamoeba spp. Infections in Southeast Asia: A Systematic Review
Patricia Andrea I. Valenciano,Amante C. Soriano,Hazel Mae L. Sisican,Eloisa Fami I. Paragas,Kayla T. Tabarina,Kaycelyn B. Ramos,Charlene Princess S. Tolenada
Asian J. Biol. Life Sci.,12(2):216-223 DOI: 10.5530/ajbls.2023.12.30 Published: Fri, 22-Sep-2023 Read More
Review Article
A Systematic Review of the Anti-proliferative Activity of Algae-synthesized Silver Nanoparticles against Cancer Cell Lines
,Jan Gabrielle, , , ,Jose Ricardo, ,Jenelle Audrey, ,Ma. Lindsay Joy, ,Eloisa Jane, ,Ronuel Kenn,Ma Prias,Catherine Anne Jhennifer, ,Pamela Rose
Asian J. Biol. Life Sci.,12(2):224-229 DOI: 10.5530/ajbls.2023.12.31 Published: Fri, 22-Sep-2023 Read More
Rev
A Narrative Review on the Preanalytical Sample Errors in the Hematology Section of Clinical Laboratory
Lissa Lourein Vi Lorque,Kristel Aryanna Me Bonifacio,Irish Gonzales Padilla,Marie Isabelle S. Panganiban,Asela Gabrielle Persia,Rochel Diaz Tsai,Reymund Miguel Mabbagu
Asian J. Biol. Life Sci.,12(2):230-236 DOI: 10.5530/ajbls.2023.12.32 Published: Fri, 22-Sep-2023 Read More
Research Article
Comparison of Tree Species Diversity and Usage by Ratufa indica indica in Umblebyle Range Forest, Bhadravathi Division, Shimoga, Karnataka, India
Hamsa Rekha Venkatesh,Shwetha Alavandi
Asian J. Biol. Life Sci.,12(2):237-244 DOI: 10.5530/ajbls.2023.12.33 Published: Thu, 28-Sep-2023 Read More
Research Article
Determination of Polycyclic Aromatic Hydrocarbons (PAHs) and their Sources in Ganga River Water, Uttar Pradesh, India
Poonam Sonwani,Chetan Singh
Asian J. Biol. Life Sci.,12(2):245-252 DOI: 10.5530/ajbls.2023.12.34 Published: Fri, 22-Sep-2023 Read More
Research Article
Trianthema decandra Root Extract and Cisplatin Action on Biochemical and Histological Characterization of Oral Cancer in DMBA-induced Preclinical Hamster Model
Marimuthu Porkodi,Ganapathy Sindhu,Kumarasamypillai Radha Thay Asha,Veerasamy Vinothkumar,Pachaiappan Pugalendi,Balakrishnan Vaitheeswari
Asian J. Biol. Life Sci.,12(2):253-262 DOI: 10.5530/ajbls.2023.12.35 Published: Tue, 13-Feb-2024 Read More
Research Article
Biosynthesis of Zinc Oxide Nanoparticles from Soil Fungi and their Characterization by Using Analytical Methods
Amitha Ganapathy Bottangada,Akarsh Subhakar,Sowmya Hirakannav Veeranna,Thippeswamy Basaiah
Asian J. Biol. Life Sci.,12(2):263-270 DOI: 10.5530/ajbls.2023.12.36 Published: Fri, 22-Sep-2023 Read More
Research Article
Suitability of Growth Media and Carbon Source for EPS Production by Lysinibacillus macroides
Kartik Andharia,Prateek Shilpkar,Mayur Shah,Susanta Kundu
Asian J. Biol. Life Sci.,12(2):271-278 DOI: 10.5530/ajbls.2023.12.37 Published: Fri, 22-Sep-2023 Read More
Research Article
Nutrient Analysis, Phytochemical and Antioxidant Activity of a Food Product Formulated with Fox Nuts (Euryale ferox)
Amanda Joseph,Gowri Ramesh
Asian J. Biol. Life Sci.,12(2):279-285 DOI: 10.5530/ajbls.2023.12.38 Published: Fri, 22-Sep-2023 Read More
Research Article
Evaluation of Combinational Therapy of L-Arginine with Some Phenolic Acids in Paclitaxel-induced Neuropathic Pain
Shubhangi Pawar,Amrapali Pagare,Suvarna Katti,Rupali Patil,Manisha Tayde
Asian J. Biol. Life Sci.,12(2):286-293 DOI: 10.5530/ajbls.2023.12.39 Published: Fri, 22-Sep-2023 Read More
Research Article
Structural, Optical, Antibacterial and Anticancer Properties Silver Barium Modified Titanium Dioxide Nanoparticles Prepared via a Green Process Using Withania somnifera Hairy Roots
Raja Palusamy,Thiagu Ganesan,Appakan Shajahan,Thilip Chandrasekaran,Alagar yadav Sangilimuthu,Liyahathalikhan Umaralikhan
Asian J. Biol. Life Sci.,12(2):294-300 DOI: 10.5530/ajbls.2023.12.40 Published: Fri, 22-Sep-2023 Read More
Research Article
Molecular Characterization and Homology Modeling of Intercellular Adhesion Regulatory (IcaR) Proteins in Biofilm-Producing Staphylococcus Species
Donmig Jaula Cunanan,Patricia Cristina N. Gonzalvo,Matthew Lauren Cum Gochuico,Charlotte Diane Vill Falzado,Acelah Estrada Cruz,Emmanuel Pastolero Dejapa,Chloe Reyna Mae Godin,Trisha Nicole Rey Fenix,Mary Rose Ferre Lirio
Asian J. Biol. Life Sci.,12(2):301-309 DOI: 10.5530/ajbls.2023.12.41 Published: Fri, 22-Sep-2023 Read More
Research Article
Effects of Stocking Density on the Growth and Survival of Nile Tilapia (Oreochromis niloticus) Fry in Floating Cages in Togo
Seme Kpassi,Lamboni Matéyendou,Assai Kébalo Gnimwè,Bidifayi Mousbaou,Pitala Wéré
Asian J. Biol. Life Sci.,12(2):310-316 DOI: 10.5530/ajbls.2023.12.42 Published: Fri, 22-Sep-2023 Read More
Research Article
Ultra-diluted Arsenic Trioxide Induced Cytokine Changes in HepG2 Cell Line
Bahnishikha Singh,Debasmita Chatterjee,Sanket Bandyopadhyay,Satadal Das
Asian J. Biol. Life Sci.,12(2):317-325 DOI: 10.5530/ajbls.2023.12.43 Published: Fri, 22-Sep-2023 Read More
Research Article
Atlas of Cyathodium Kunze Species from India
Sarath Ramesan Ve Vayalil,Sunukumar Soma Syamala,Manoj Gopal Sarayu
Asian J. Biol. Life Sci.,12(2):326-331 DOI: 10.5530/ajbls.2023.12.44 Published: Tue, 3-Sep-2024 Read More
Research Article
Study on Prevalence and Antimicrobial Susceptibility Patterns of Clinical Isolates in a Tertiary Care Teaching Hospital
Shanmugam Sriram,Ashmi C,Mercy Grow Martin,Nanthini Moorthy,Nivedha Karthikeyan,Preetha Kumar
Asian J. Biol. Life Sci.,12(2):332-342 DOI: 10.5530/ajbls.2023.12.45 Published: Wed, 27-Sep-2023 Read More
Research Article
Phytoremediation, Antioxidant, Antimicrobial Activity of Callisia repens Silver Nanoparticles
Namamurali Praneetha,Suchitra Naidu,Sabitha Yadam
Asian J. Biol. Life Sci.,12(2):343-351 DOI: 10.5530/ajbls.2023.12.46 Published: Fri, 22-Sep-2023 Read More
Research Article
Proximate Biochemical Composition and Antinutritional Analyses of the Selected Parts of Yacon (Smallanthus Sonchifolius)
Merlyn Galagar Gonzales,Romeo Macaltao Del Rosario,Angelo Mark Po Walag
Asian J. Biol. Life Sci.,12(2):352-358 DOI: 10.5530/ajbls.2023.12.47 Published: Fri, 22-Sep-2023 Read More
Research Article
Enhancement of Production of Exopolysaccharides from Bacillus Species
Rajendrabhai Daulatbhai Vasait,Ahire Vanita Laxman,Sonawane Pooja Hemant,Deoghare Neha Subhash,Borse Archana Ashok
Asian J. Biol. Life Sci.,12(2):359-368 DOI: 10.5530/ajbls.2023.12.48 Published: Fri, 22-Sep-2023 Read More
Research Article
Malacofauna of Village Tanks and Minor SeasonalWater Bodies from Upper Deccan Plateau Ahmednagar Maharashtra
Pande Gajanan Sukhdeo,Lonkar Rahul S.,Rayate Dadasaheb Ashok,Patil Sachin Ramsing
Asian J. Biol. Life Sci.,12(2):369-375 DOI: 10.5530/ajbls.2023.12.49 Published: Fri, 22-Sep-2023 Read More
Research Article
Evaluation of Duhat (Syzygium cumini) Leaves as Cytological Stain
Sabanal Atheena Khassandra,Reyes Maria Angela,Reyes Norvin Jay,Soriano Ruff Renn,Tolentino Shanel,Veneracion John Bryan,Ventenilla Ansel Ian,Vizconde Danica Gabrielle,Bremner Pamela Rose
Asian J. Biol. Life Sci.,12(2):376-385 DOI: 10.5530/ajbls.2023.12.50 Published: Fri, 22-Sep-2023 Read More
Research Article
The Effect of High Fructose Corn Syrup on SCC-9 Cells Regulated by G0/G1 Cell Cycle Arrest via Apoptosis Induction
Kalimuthu Kavitha,Ganapathy Sindhu,Marimuthu Porkodi,Kumarasamypillai Radha Thay Asha,Veeran Veeravarmal,Annamalai Vijayalakshmi
Asian J. Biol. Life Sci.,12(2):386-394 DOI: 10.5530/ajbls.2023.12.51 Published: Fri, 22-Sep-2023 Read More
Research Article
Assessment of the Effect of Methanolic Herbal Extract on Cocoon Parameters and Tensile Properties of Silk Fiber Spun by Beauveria bassiana Infected Muga Silkworm, Antheraea assamensis Helfer
Sanghamitra Saharia,Shibani Kalita,Dimpimoni Kalita,Anjumani Ojah,Sunayan Bardoloi
Asian J. Biol. Life Sci.,12(2):395-401 DOI: 10.5530/ajbls.2023.12.52 Published: Fri, 22-Sep-2023 Read More
Research Article